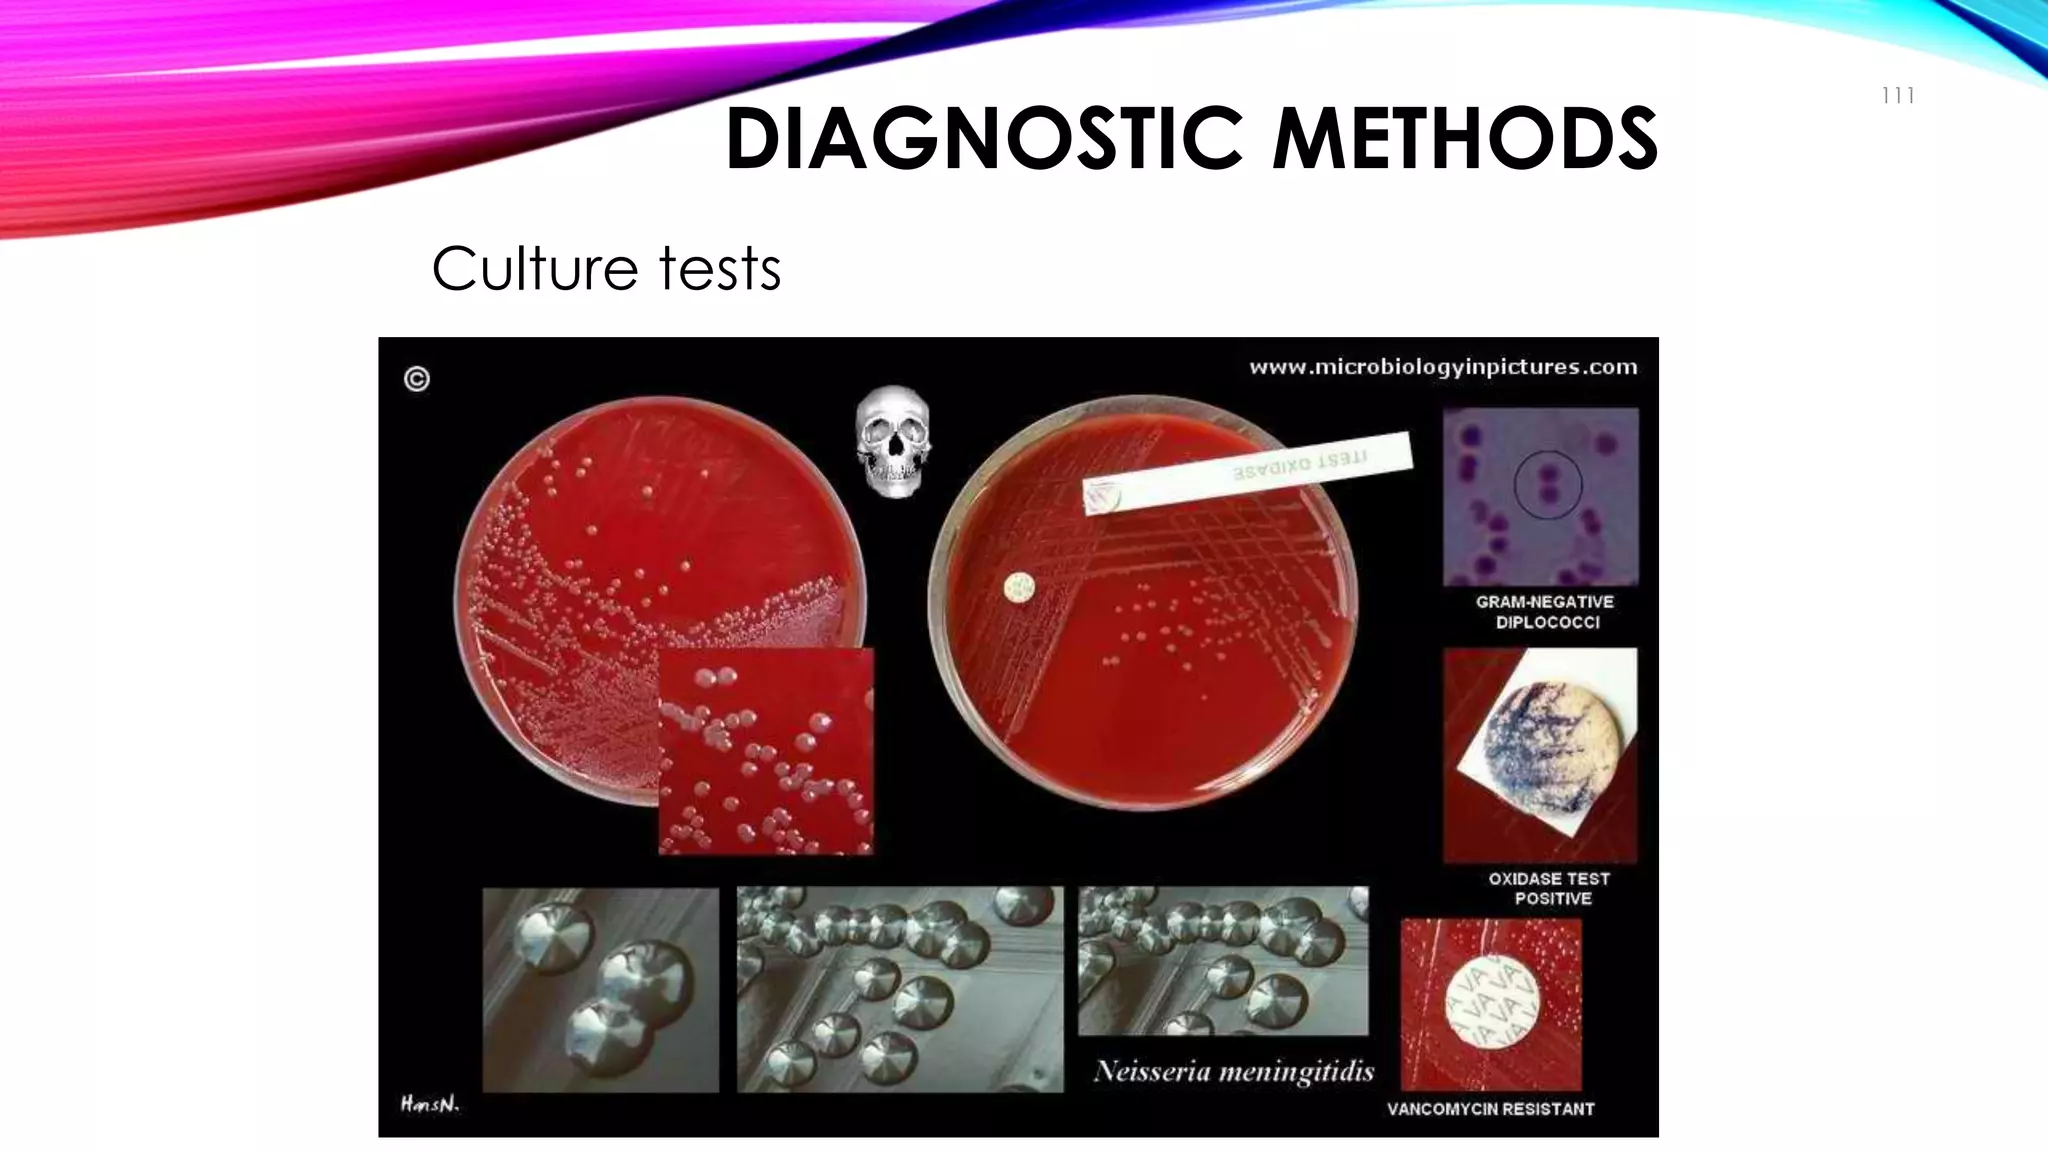
DIAGNOSTIC METHODS
• Culture tests
111
Diagnosis

Microbes play an important role in causing infectious diseases. They can enter the body through various portals of entry and cause localized or systemic infections depending on factors like virulence and host defenses. Diseases may be communicable through direct or indirect contact or non-communicable if the agent normally inhabits the body. Microbes have specific biological requirements for oxygen, nutrients, temperature, pH and other factors that influence their ability to cause infection.